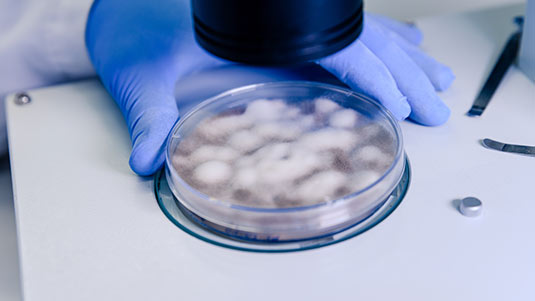

Cryopreservation (Oocyte & Sperm)
Preserving Fertility for Your Future
At Rusiya Fertility Centre, we offer advanced Cryopreservation services for oocytes (eggs) and sperm, enabling individuals and couples to preserve their fertility for future family planning. Whether you are undergoing medical treatment, planning to delay parenthood, or part of an IVF cycle, cryopreservation provides the flexibility and security to conceive when the time is right.



What is Cryopreservation?
Cryopreservation is the process of freezing and storing reproductive cells—eggs (oocytes), sperm, or embryos—at extremely low temperatures using liquid nitrogen. These cells can be safely thawed and used later in fertility treatments such as IVF or ICSI.
Who Can Benefit from Cryopreservation?
- Women wishing to delay childbearing (social egg freezing) recurrent miscarriage)
- Men or women undergoing cancer treatments (chemotherapy/radiation)
- Couples undergoing IVF (to store extra embryos or eggs)
- Men with low sperm count or before surgery affecting fertility
- Donor egg or sperm preservation
- High-risk professions (e.g., military personnel)

Our Cryopreservation Process
- Initial Consultation & Assessment
Evaluation of fertility potential, medical history, and timing for freezing. - Collection of Gametes
Eggs are retrieved after ovarian stimulation; sperm is collected naturally or surgically. - Freezing & Storage
Using vitrification (rapid freezing), gametes are stored safely in specialized cryotanks. - Long-Term Storage
Cryopreserved samples are stored securely, with regular monitoring and strict safety protocols. - Thawing & Use in Treatment
Frozen eggs/sperm are thawed when ready for use in IVF, ICSI, or IUI treatments.
Skilled Hands, Compassionate Hearts
Dr. V. Anand Mohan
Founder
Kareem V.M
Managing Director
Dr. Bushera
Director of Operations &
Embryologist
Dr. Premu Johnson
Senior Consultant in Obstetrics & Gynecology
Dr. Balakrishnan
Senior Gynecologist &
Infertility Specialist
Dr Narayanan
Psychologist
Dr. Krishnaa Prakash
Consultant Sexologist
Ann Maria K.J
Junior Embryologist
Why Choose Rusiya Fertility Centre?
At Rusiya Fertility Centre, we use the latest vitrification technology for safe and effective freezing of eggs and sperm. Our expert team offers personalized care for both medical and personal fertility preservation needs, ensuring secure long-term storage, confidentiality, and affordable services. We support you at every step with compassion and precision.
Latest vitrification technology for safe, high-survival freezing
Expertise in fertility preservation for medical and personal reasons
Secure, long-term storage with monitoring
Ethical, confidential, and affordable services
Personalized care and counseling at every step
RUSIYA
Fertility Center


RUSIYA
Fertility Center
Schedule Your Cryopreservation Consultation Today
Whether you’re planning for the future or starting fertility treatment now, advanced cryopreservation offers peace of mind, reproductive freedom, and personalized care. Let Rusiya Fertility Centre help you preserve your fertility safely, effectively, and confidently.
Frequently Asked Questions
Egg freezing is most effective before age 35, when egg quality and quantity are optimal.
They can be safely stored for 10 years or longer, depending on legal guidelines and individual needs.
Yes. With vitrification, survival rates after thawing are high, and frozen samples remain healthy for use.
To preserve fertility before medical treatments, delay parenthood, or as part of an IVF cycle.
Coverage varies. We offer affordable plans, and our team can guide you on financial options.
Yes. Frozen gametes are thawed and used in IVF, ICSI, or IUI treatments when you’re ready to conceive.
- Copyright 2025 Rusiya Fertility Center.
Powered by SilverHost








